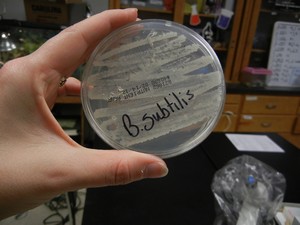

AP Biology
AP Biology
Unit 4: Pathology
How Much Do You Know About Diseases - group activity
Disease Sorting Activity - introduction and classification of disease
Disease Infographic - create an informational graphic on a disease of your choice
Disease Transmission (Postulates)
(Case Study) John Snow and the Origin of Epidemiology
(Video) Viral Replication
(Case Study) How to Survive Cholera
(Animations) Replication of a Retrovirus | Viral Lifecycle by HHMI | HIV Replication
(Video) Bacteria
(Case Study) Antibiotic Resistance
(Videos) The Immune System (BZ) | The Immune System (CC)
(Animation) The Immune Response
(Interactive) The Adaptive Immune Response at HHMI